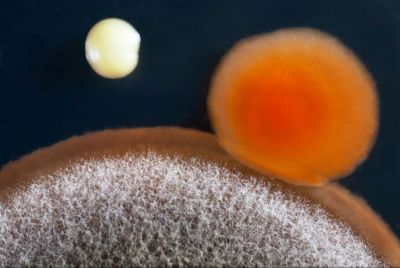
A microscopic look at three different germs and molecules

Are UV Lights Worth the Cost?

Should you install UV lights?
Installing UV lights into your HVAC system is a great way to improve your indoor air quality and reduce the number of harmful particles.
UV sanitation systems help keep your air safe and free of viruses, bacteria, mold, and fungi. When combined with a good air filter, you can create indoor air that's as clean and healthy as outdoor air.
In this blog, we'll answer some of the biggest questions that help determine value when it comes to UV light installation, including:
- What Is a UV Light Air Purifier?
- How Do UV Lights Work and What Are Their Benefits?
- What Are UV Lights Effective Against?
- How Much Do UV Lights Cost to Install?
Once you know what UV lights can do for your home and how much they cost, you can make a better decision about value.
Are You Ready to Explore Installing UV Sanitation Systems Directly into Your HVAC System?
Get the family treatment when you call and speak with the courteous and knowledgeable air quality experts at Red Cap Air and Plumbing. We'll answer all your questions about the best ways to protect your home and your family.
What Is a UV Light Air Purifier?
A UV light air purifier is a system that works on specific types of particles that can spread diseases or other infections. Unlike a filter that traps particles larger than a certain size, a UV light purifier works directly on specific types of particles, killing the bacteria, viruses, or mold cells that could otherwise make members of your household sick.
UV light purifiers come in two basic styles and setups:
- Coil-cleaning: UV lights installed near your AC's evaporator coil are called coil-cleaning UV lights. This location offers significant benefits since they have access to the air making its way through your home. Being placed in the AC system where condensate occurs allows these lights to attack viruses and bacteria where they're most likely to form and keeps your unit free from spores and other cells that could destroy your system over time.
- Air-cleaning: Air-cleaning UV lights fit near the return intake for your ductwork system and sanitize air before it enters the cooling system.
Your home's individual architecture and HVAC system will determine the best placement. Talk to one of our experienced technicians to determine which location is best or if you could benefit from installing UV lights at both placements.
How Do UV Lights Work and What Are Their Benefits?
UV lights can render bacteria harmless.
Since UV lights can kill bacteria, viruses, mold, and other particles that can cause illnesses, they are a great way to keep every member of your household breathing easily. Reducing exposure to mold spores and other fungi can greatly benefit family members with asthma or other respiratory conditions.
In areas with high humidity like Florida, mold easily grows. UV lights can effectively preserve your health by preventing your evaporator coil and drain pan from becoming breeding grounds for mold.
UV lights also help to extend the life of your air conditioner. Any contaminant growth which inhibits airflow makes your unit work harder to keep your home cool. By killing off cells that replicate and create illnesses, you also help keep air flowing smoothly through your system. Plus, strained AC systems cost more to run, making UV lights a win/win regarding financial savings.
What UV Lights Are Effective Against?
UV lights are effective against virtually all viruses, bacteria, mold, and fungi that pass directly through the rays. Any microorganism larger than 0.01 microns can be rendered ineffective by UV lights. While these systems can't combat every type of cold or flu virus, they are effective against most and can reduce the spread of diseases through your home. Bacteria have no good place to grow when faced with UV lights, reducing your chances of contracting illnesses like pneumonia.
How Much Does It Cost to Install UV Lights in My HVAC System?

Most UV lights are installed within HVAC systems.
Installing UV lights is fairly affordable for a major home project, though the cost can vary dramatically depending on the system you need.
In general, air-sterilizing lights are the more expensive option for installation. Because these systems have a high wattage and produce more UV-C light, the units are more expensive, driving up the total cost of installation. Coil-sterilizing lights don't need as much power since they are more focused on a specific area, and the lights don't have as much space to diffuse. Expect to pay the most if you install a system that uses both types of UV sterilization.
While trying a DIY installation for these lights might be tempting, errors during the process can make them ineffective, rendering any savings moot. Professional installation is fast, reliable, and won't leave you calling for help in the middle of the job.
So, Is Installing UV Lights in Your HVAC System Worth It?
In many cases, the answer is a clear yes! It's worth installing UV lights solely for the benefits that extend the life of your HVAC system. However, the added benefits of improved health and respiratory wellness make it a solid investment toward protecting you and your loved ones.
In fact, you may even want to upgrade to a UV filtration system to maximize your benefits. A UV filtration system combines the virus and bacteria-killing power of UV lights with a high-MERV filter to trap other particles that can trigger respiratory distress, such as pollen and dust.
Still Have Questions About UV Lights? Ask Red Cap!

Contact Red Cap for reliable and efficient UV light installations in Tampa.
Our fast and convenient scheduling and honest prices mean you can get fresh air indoors without worry! We're happy to answer all of your questions and explain which types of UV lights are best for your home setup. From Brandon to Westchase, we've improved indoor air quality for hundreds of Florida homeowners.
Call or schedule an appointment online today for a free consultation!
